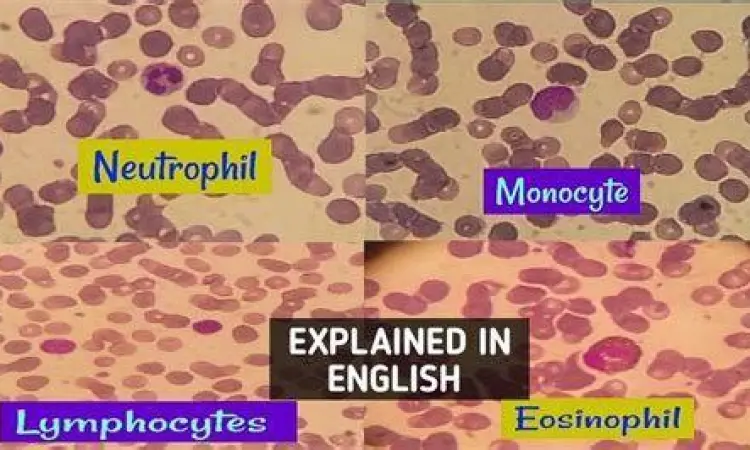
Tampilan neutrofil dan limfosit

Sel Darah Putih dan Peran Vitalnya dalam Sistem Imun Tubuh
Sel darah putih, atau yang secara medis dikenal sebagai leukosit, merupakan komponen fundamental dalam sistem sirkulasi manusia yang berfungsi sebagai perisai utama melawan berbagai ancaman eksternal. Meskipun jumlahnya jauh lebih sedikit dibandingkan sel darah merah, peran sel darah putih tidak dapat diremehkan karena tanpa keberadaannya, tubuh manusia akan sangat rentan terhadap serangan patogen seperti bakteri, virus, jamur, hingga parasit yang ada di lingkungan sekitar. Memahami cara kerja komponen ini sangat penting bagi siapa saja yang ingin menjaga kualitas kesehatan secara jangka panjang.
Secara biologis, sel darah putih diproduksi di sumsum tulang dan kemudian didistribusikan melalui aliran darah serta sistem limfatik ke seluruh jaringan tubuh. Masa hidup sel ini bervariasi, mulai dari beberapa jam hingga hitungan tahun, tergantung pada jenis dan tugas yang dijalankannya. Ketika terjadi infeksi atau peradangan, tubuh akan secara otomatis merespons dengan memicu produksi leukosit tambahan untuk segera dikirim ke area yang bermasalah. Fenomena ini menunjukkan betapa dinamis dan responsifnya mekanisme pertahanan biologis manusia terhadap ancaman luar.
Mengenal Fungsi Utama Sel Darah Putih bagi Tubuh
Fungsi utama dari sel darah putih adalah untuk mengidentifikasi, menyerang, dan menetralisir benda asing yang masuk ke dalam tubuh. Mereka bertindak layaknya unit keamanan yang berpatroli tanpa henti di dalam pembuluh darah. Berikut adalah beberapa rincian mendalam mengenai fungsi krusial yang mereka jalankan:
- Fagositosis: Proses di mana sel-sel tertentu menelan dan mencerna mikroorganisme atau partikel asing yang berpotensi membahayakan.
- Produksi Antibodi: Beberapa jenis leukosit bertugas menciptakan protein khusus yang disebut antibodi untuk menandai dan melumpuhkan virus atau bakteri spesifik secara efektif.
- Respons Peradangan: Sel darah putih melepaskan zat kimia yang memicu peradangan, sebuah proses penting untuk mempercepat penyembuhan jaringan yang rusak.
- Memori Imun: Menyimpan informasi tentang patogen yang pernah menyerang, sehingga tubuh dapat merespons lebih cepat jika infeksi serupa terulang kembali di masa depan.

Mekanisme Pengenalan Patogen
Setiap sel darah putih dilengkapi dengan reseptor khusus yang mampu membedakan mana sel tubuh yang sehat dan mana entitas asing yang bersifat merusak. Melalui sinyal kimia yang disebut sitokin, sel-sel ini saling berkomunikasi untuk mengoordinasikan serangan yang sistematis. Tanpa komunikasi yang baik antar-sel ini, sistem kekebalan tubuh bisa menjadi kacau, yang terkadang menyebabkan kondisi autoimun di mana sel sehat justru diserang oleh leukosit sendiri.
Jenis dan Klasifikasi Sel Darah Putih
Leukosit bukanlah satu jenis sel tunggal, melainkan sebuah kelompok sel yang terdiri dari lima jenis utama, masing-masing memiliki spesialisasi tugas yang berbeda. Pembagian ini sangat penting dalam diagnosis medis karena perubahan jumlah pada jenis tertentu dapat mengindikasikan jenis penyakit yang spesifik pula.
| Jenis Leukosit | Persentase Normal | Fungsi Utama |
|---|---|---|
| Neutrofil | 50% - 70% | Melawan infeksi bakteri dan jamur dengan cara fagositosis. |
| Limfosit | 20% - 40% | Menghasilkan antibodi dan melawan infeksi virus. |
| Monosit | 2% - 8% | Bertindak sebagai pembersih sel-sel mati dan kuman berukuran besar. |
| Eosinofil | 1% - 4% | Merespons reaksi alergi dan melawan infeksi parasit atau cacing. |
| Basofil | 0,5% - 1% | Melepaskan histamin untuk memicu respons peradangan saat ada ancaman. |
Setiap jenis sel darah putih tersebut harus berada dalam keseimbangan yang tepat agar tubuh tetap sehat. Jika salah satu jenis mengalami lonjakan atau penurunan drastis, hal tersebut bisa menjadi pertanda adanya gangguan kesehatan mulai dari alergi ringan hingga kondisi serius seperti kanker darah atau leukemia.
Peran Spesifik Neutrofil dan Limfosit
Neutrofil adalah unit tanggap cepat yang pertama kali tiba di lokasi infeksi. Mereka sangat agresif dalam menghancurkan bakteri namun memiliki masa hidup yang cukup singkat. Di sisi lain, limfosit yang terdiri dari sel B dan sel T merupakan kunci dari sistem imun adaptif. Sel B bertanggung jawab memproduksi antibodi, sedangkan sel T berperan langsung dalam membunuh sel yang telah terinfeksi virus atau sel kanker secara presisi.
Mengapa Kadar Sel Darah Putih Bisa Berubah
Fluktuasi jumlah sel darah putih dalam tubuh adalah hal yang lumrah, namun jika angka tersebut berada di luar batas normal (umumnya antara 4.500 hingga 11.000 sel per mikroliter darah), maka dokter biasanya akan melakukan investigasi lebih lanjut. Perubahan kadar ini dipengaruhi oleh banyak faktor internal maupun eksternal.
"Jumlah sel darah putih yang tinggi sering kali merupakan sinyal bahwa tubuh sedang berjuang keras melawan infeksi, sedangkan jumlah yang rendah bisa menunjukkan adanya kerusakan sumsum tulang atau efek samping obat-obatan tertentu."
Beberapa penyebab umum meningkatnya kadar leukosit (leukositosis) antara lain adalah infeksi akut, stres fisik atau emosional yang berat, merokok, serta peradangan kronis seperti arthritis. Sebaliknya, penurunan kadar (leukopenia) dapat disebabkan oleh penyakit autoimun (seperti Lupus), infeksi virus parah (seperti HIV/AIDS), paparan radiasi, atau efek dari kemoterapi.
Gejala dan Dampak Ketidakseimbangan Leukosit
Ketika kadar sel darah putih tidak seimbang, tubuh biasanya akan menunjukkan tanda-tanda klinis. Meski gejalanya seringkali tidak spesifik, mengamati sinyal tubuh dapat membantu dalam deteksi dini masalah kesehatan yang mendasari.
- Kadar Tinggi: Sering disertai demam, keringat malam, penurunan berat badan yang tidak dapat dijelaskan, serta memar yang muncul tiba-tiba.
- Kadar Rendah: Tubuh menjadi sangat mudah terserang infeksi, sering mengalami sariawan, luka yang lama sembuh, dan rasa lemas yang berkepanjangan.
Ketidakseimbangan kronis pada sel darah putih dapat berdampak buruk pada kemampuan tubuh untuk menyembuhkan diri. Tanpa jumlah yang memadai, infeksi ringan seperti flu atau luka kecil dapat berkembang menjadi komplikasi yang mengancam jiwa. Oleh karena itu, pemeriksaan darah rutin melalui tes Hitung Darah Lengkap (Complete Blood Count/CBC) sangat disarankan untuk memantau status kesehatan leukosit secara berkala.

Menjaga Perisai Alami Tubuh Agar Tetap Tangguh
Mengingat peran strategis sel darah putih dalam menjaga kelangsungan hidup, upaya untuk mendukung kesehatan sistem imun harus menjadi prioritas harian. Gaya hidup memegang peranan kunci dalam memastikan sumsum tulang dapat memproduksi leukosit yang berkualitas dan dalam jumlah yang cukup. Konsumsi makanan yang kaya akan vitamin C, vitamin D, zinc, dan protein sangatlah esensial, karena zat gizi ini merupakan bahan baku utama bagi perkembangan sel imun.
Selain nutrisi, manajemen stres dan tidur yang berkualitas juga memiliki pengaruh langsung terhadap aktivitas leukosit. Stres kronis melepaskan hormon kortisol yang dapat menekan produksi sel darah putih, sehingga melemahkan sistem pertahanan tubuh. Melakukan aktivitas fisik yang rutin namun tidak berlebihan juga diketahui dapat melancarkan sirkulasi darah, sehingga leukosit dapat berpatroli ke seluruh bagian tubuh dengan lebih efisien.
Sebagai langkah pamungkas, hindarilah kebiasaan merokok dan konsumsi alkohol berlebih yang dapat merusak integritas sel darah putih. Melakukan pemeriksaan kesehatan secara rutin bukan hanya sekadar untuk mengobati penyakit, tetapi merupakan bentuk investasi untuk memahami kondisi internal tubuh kita sendiri. Dengan menjaga kadar sel darah putih tetap berada pada rentang ideal, kita memberikan kesempatan bagi tubuh untuk tetap tangguh dalam menghadapi tantangan lingkungan yang semakin kompleks di masa depan.
What's Your Reaction?
-
0
Like -
0
Dislike -
0
Funny -
0
Angry -
0
Sad -
0
Wow